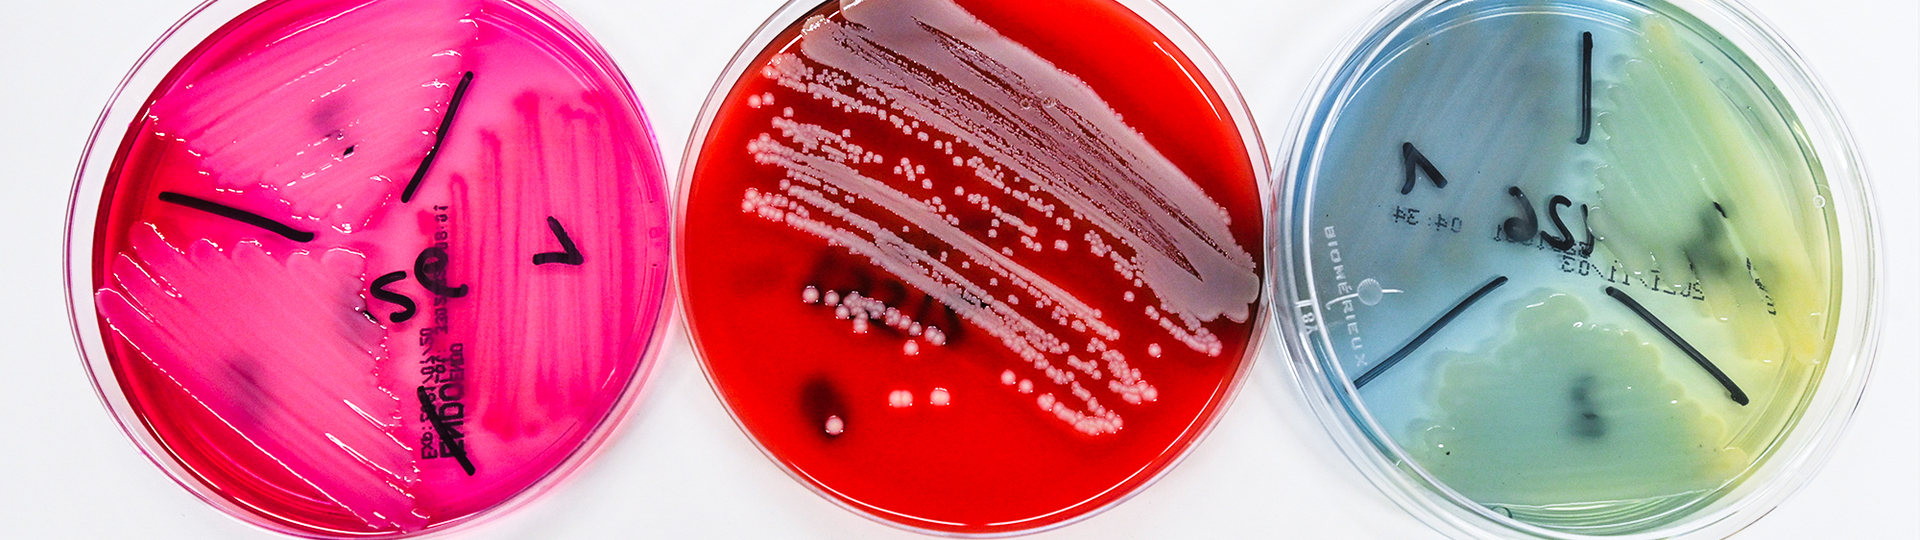

Klinische Pathologie und Mikrobiologie
- Leitung & Team
Herzlich willkommen!
Was viele vielleicht nicht wissen: Die Pathologie, also die Lehre von der Krankheitsentstehung, spielt heutzutage eine wesentliche Rolle in der Behandlung der Patientinnen und Patienten. Mehr als 95 Prozent unserer Befunde werden – entgegen dem landläufigen Bild von der Pathologie – für lebende Menschen erstellt.
Das Landesinstitut für klinische Pathologie und Mikrobiologie betreut als ein zentrales klinisch-diagnostisches Fach mit ausgeprägter interdisziplinärer Vernetzung die vier Standorte der Burgenländischen Krankenanstalten-Gesellschaft m.b.H. sowie einzelne niedergelassene Ärztinnen und Ärzte.
Am Institut untersuchen wir histologisch und zytologisch Organe oder Organteile, die bei chirurgischen Eingriffen (beziehungsweise Operationen) entfernt werden, ebenso wie endoskopisch-bioptisch gewonnene Gewebsproben. Damit finden wir krankhafte Organ-Gewebsveränderungen (Tumordiagnostik). Histopathologische Untersuchungen während einer Operation mittels Gefrierschnitttechnik beeinflussen das Ausmaß eines chirurgischen Eingriffes unmittelbar.
Zellen und Zellverbände aus Ergüssen in Körperhöhlen, Harn und Abstrichen analysieren wir mit den Methoden der Zytologie. Eine weitere Aufgabe des Instituts ist die mikrobiologische Diagnostik von krankheitsauslösenden Bakterien. Im bakteriologischen Labor testen wir, wie empfindlich Keime gegenüber Antibiotika sind.
Im serologischen Labor machen wir infektionsserologische Untersuchungen (zum Beispiel weisen wir Borreliose nach).
Überdies führen wir klinische Autopsien in allen vier Kliniken sowie die sanitätsbehördlichen Obduktionen für das gesamte Burgenland durch.
Kontakt:
Klinische Pathologie und Mikrobiologie
Sekretariat
Sabine Lang
05 7979 52542 (Personenbezogene Gesundheitsdaten dürfen aufgrund der gültigen gesetzlichen Bestimmungen seit 1.1.2025 nicht mehr gefaxt werden. Zuweiser*innen werden gebeten, Gesundheitsdaten über folgende DaMe-Adresse zu übermitteln: GB078100)
Leitung & Team
Erste Oberärztin:
OÄ Dr.in Margit Deutsch-Höfler
Oberärztinnen:
OÄ Dr.in Nadja Moritz
OÄ Dr.in Alina Schein
OÄ Dr.in Dana Unguras
Fachärzt*innen:
FÄ Dr.in Marie Hader
FÄ Dr.in Martina Pairits
FA Dr. Tamas Lotz
Assistenzärzt*innen:
Ass.-Dr. Nico Pesenhofer
Ass.-Dr. Andras Mor
Leitung histologisches Labor:
BMA Rita Hammerl
BMA Katrin Herbst (Stv.)
Leitung mikrobiologisches Labor:
BMA Claudia Neubauer
BMA Flora Winkler (Stv.)
Sekretariat:
Sabine Lang (Ltg.)
Lisa Engelmayer (Stv.)
Sabine Petermann-Zumpf